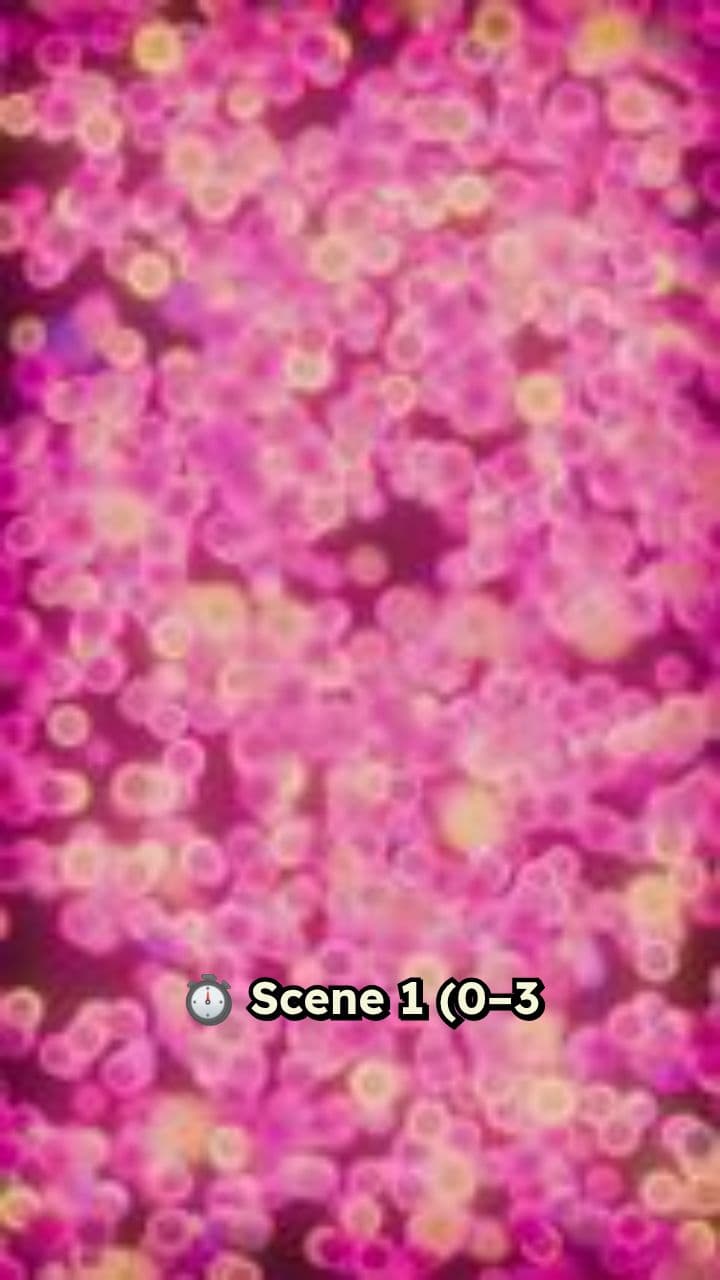
Trimbak Financial Services: Transparent Loan Help

AI Generated Video
Susan Powell Predicted Her Own Disappearance
S
Created January 3, 2026About this video
Check out this video I made with revid.ai
Try the YouTube Clip Maker
Create your own version in minutes
Impact
240,909+ Short Videos
Created By Over 14,258+ Creators
Whether you're sharing personal experiences, teaching moments, or entertainment - we help you tell stories that go viral.
No credit card required